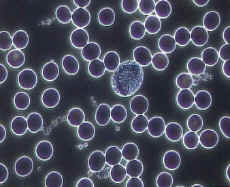
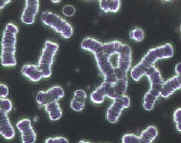

血液分析


從您的指尖抽取一滴活血的樣本,然後透過電子光學顯微鏡將您血液內細胞的功能及活動情況,活生生呈現在您的眼前。您可即時知道隱藏在您血清內的膽固醇或尿酸晶體是否過高、紅血球的帶氧功能是否過弱、紅/白血球是否正常、體內是否有霉菌、真菌、念珠菌寄生、重金屬毒素是否過多、是否有糖尿病傾向、肝功能是否正常;有了這些第一手的資料,我們的醫學顧問便可即時以先進的預防醫學,為您的健康作出最有效的保障。
預防勝於治療
![image001[1]](http://www.nw2003.com/image/catalog/old/blood_analysis/image003.jpg) 其實「超高解像人體活血分析」,已經被美國及歐洲很多自然療法及另類療法的醫生用來診斷及預防疾病之用。其中運用「相位差 Phase Contrast」的光學原理,發現細菌或念珠菌的形成過程,充分把握預防及治療疾病的先機;另外配搭「暗視野 Darkfield」的聚物光學原理,讓我們親眼目睹自己紅血球細胞的形狀、大小、黏稠度及色澤;白血球的活動能力及數量;飲食不均衡所造成的尿酸結晶、壞膽固醇結晶或糖類代謝不良的結晶沉澱情況,還有血管栓塞物、重金屬毒素積聚的數目及大小;每種表現皆可顯示您身體所潛伏的危機!
其實「超高解像人體活血分析」,已經被美國及歐洲很多自然療法及另類療法的醫生用來診斷及預防疾病之用。其中運用「相位差 Phase Contrast」的光學原理,發現細菌或念珠菌的形成過程,充分把握預防及治療疾病的先機;另外配搭「暗視野 Darkfield」的聚物光學原理,讓我們親眼目睹自己紅血球細胞的形狀、大小、黏稠度及色澤;白血球的活動能力及數量;飲食不均衡所造成的尿酸結晶、壞膽固醇結晶或糖類代謝不良的結晶沉澱情況,還有血管栓塞物、重金屬毒素積聚的數目及大小;每種表現皆可顯示您身體所潛伏的危機!
如何從一滴血液看健康
● 正常的紅血球
正常的紅血球像似雙凹不通透的鮮紅色棋子。平均直徑為7.3 – 8.0 mm。
正常的紅血球像似雙凹不通透的鮮紅色棋子。平均直徑為7.3 – 8.0 mm。
● 中央透明的紅血球
 紅血球出現像甜甜圈型態時,顯示飲食中缺乏鐵質,或是使用藥物、內分泌失調、女性經血過多、消化不良以及飲用過多的咖啡、茶及抽煙等,易造成貧血,初期徵狀包括沒有食慾、頭痛、便秘、煩躁、疲勞及注意力無法集中。
紅血球出現像甜甜圈型態時,顯示飲食中缺乏鐵質,或是使用藥物、內分泌失調、女性經血過多、消化不良以及飲用過多的咖啡、茶及抽煙等,易造成貧血,初期徵狀包括沒有食慾、頭痛、便秘、煩躁、疲勞及注意力無法集中。
● 紅血球聚集及串連
此代表體內自由基(Free Radical)數量過多,造成帶氧及排毒功能下降,使得血液循環不良,容易疲倦,精神變差。原因大多是吸煙或二手煙、缺乏運動、飲水量不足、不均衡飲食習慣或是壓力所造成。
此代表體內自由基(Free Radical)數量過多,造成帶氧及排毒功能下降,使得血液循環不良,容易疲倦,精神變差。原因大多是吸煙或二手煙、缺乏運動、飲水量不足、不均衡飲食習慣或是壓力所造成。
● 水雷狀紅血球
 當進食過多單糖類食物如汽水、朱古力、甜品、白糖等,有些紅血球就會變成畸形化,呈現出「針型棘狀」如水雷狀一樣;家族中如有人患糖尿病的人在血液也會看到這些水雷狀的紅血球。
當進食過多單糖類食物如汽水、朱古力、甜品、白糖等,有些紅血球就會變成畸形化,呈現出「針型棘狀」如水雷狀一樣;家族中如有人患糖尿病的人在血液也會看到這些水雷狀的紅血球。
●尿酸結晶
 現代社會的飲食型態,偏好肉類、海產;素食者則偏好豆類、菇類這些高脂肪、高蛋白質的食物,如果再加上不均衡的飲食習慣,往往會造成攝取過量的脂肪及蛋白質,形成新陳代謝的負荷,「尿酸結晶」就會出現於血液中!這也是造成痛風的原因。
現代社會的飲食型態,偏好肉類、海產;素食者則偏好豆類、菇類這些高脂肪、高蛋白質的食物,如果再加上不均衡的飲食習慣,往往會造成攝取過量的脂肪及蛋白質,形成新陳代謝的負荷,「尿酸結晶」就會出現於血液中!這也是造成痛風的原因。
●血管栓塞物
 血液中如果出現深色的斑塊,也就是「血管栓塞物」,充分顯示煎炸食物及重金屬毒素積聚的結果,可要小心引致動脈硬化、癌病的潛在危機,如果不及早改善和預防,各種疾病將應運而生。
血液中如果出現深色的斑塊,也就是「血管栓塞物」,充分顯示煎炸食物及重金屬毒素積聚的結果,可要小心引致動脈硬化、癌病的潛在危機,如果不及早改善和預防,各種疾病將應運而生。
及早發現,營養治療
過去經常看見或聽到一些人平常看起來是非常健康的,但突然中風或心肌梗塞,非常可怕;而這就是「血管栓塞物」正悄悄的聚集及增加,最後阻塞血管,造成惡果。
如果我們能透過這樣簡單、快速的「超高解像人體活血分析」,瞭解自己的體質及健康狀況,及早發現;並配合飲食生活形態調節,甚至補充特定的天然營養補充品,幫助身體做好「排毒及清潔」的工作,並且加強免疫系統的功能,抵禦細菌病毒的入侵;適量補充造血元素,強化紅血球帶氧功能,以及有規律的運動習慣和生活模式,這樣才能讓自己擁有健康的身體及最佳的精神狀態!
其實,<超高解像人體活血分析>與一般化驗所的血液化驗有很大的分別:
|
超高解像活體血液分析 |
一般化驗所的血液化驗 |
|
放大20,000倍 |
最多可放大2,000倍 |
|
重「質」- 當病變未危害到身體的健康時已可觀察到 |
重「量」- 病變指數必須達至危害身體健康的程度才能察覺得到 |
|
無添加化學染色素 |
必須添加化學染色素 |
|
不經沖洗 |
必須沖洗,令血液內很多重要資料也被沖洗掉 |
|
清楚看到血清中的細菌、念珠菌及霉菌 |
一般培養基種不出這些細菌及霉菌 |
|
可直接觀察紅、白血球的活動情況 |
不能 |
|
可即時知道體內的帶氧功能 |
不能 |
|
細胞有否變型或被細菌感染,從而判斷出是否有貧血、糖尿病或免疫力受損 |
不能 |
|
清楚看到血清中淤塞血管的栓塞物、惡性膽固醇晶體或尿酸晶體 |
不能 |
|
身體重金屬污染 |
不能 |
|
可即時知道身體的健康狀況 |
起碼要等三數天 |
資料由活血細胞研究中心提供
|
收費表 |
|
包括詳細健康及病歷諮詢, 身體出現的健康問題 /症狀分析; 身心營養預防醫學建議。(約一小時) |
|
包括再做一次超高解像人體活血分析及瞭解血液形態及健康的改善。(約 30分鐘) |
|
不包括超高解像人體活血分析; 詳細瞭解健康的改善及其他建議。 (約 20分鐘) |
|
一個月的劑量收費由HK$1,000.00至HK$4,000.00。 |
備註:
- 上述費用並不包括藥品級(Pharmaceutical Grade)營養補充劑的處方。
- 所有服務,只接受預約。
- 只接受現金和信用卡。
Call (852)34253537 for an appointment!
